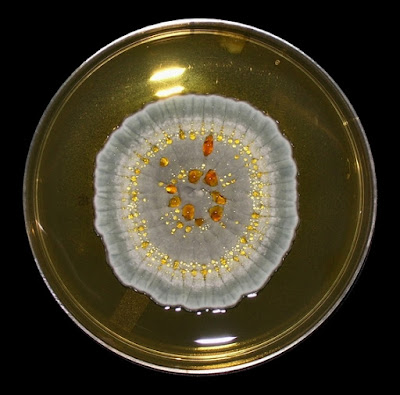

Penicillium citrinum
Ecology: Penicillium citrinum is a commonly occurring filamentous fungus with worldwide distribution. It has been isolated from a variety of sources including soils, decaying vegetation, foodstuffs (beans, coffee, cereals & spices) as well as a variety of indoor environments.
Pathology: While Penicilliumspecies are generally regarded as laboratory contaminants, or at best, opportunists, a number of species have been implicated as being involved in the disease process. While Penicillium species may be isolated from clinical specimens, it is commonly believed that a true infection can only be established by histological demonstration of tissue invasion. With that in mind, Penicillium citrinum has been reported in mycotic keratitis (eye), lung infections (pneumonia), a single case of a urinary tract infection (UTI) and one of pericarditis. Their contribution to the disease process may be secondary an additional underlying illness. As with all fungi, immunocompromised individuals may be at greater risk of infection including those rarely considered as pathogenic.
Macroscopic Morphology: Penicillium citrinum exhibits moderately slow growth on Sabouraud-Dextrose agar (SAB) at 30ᵒC. Surface texture is velutinous (soft, velvety surface) to floccose (woolly tufts of soft “hairs”). The colonial growth appears radially sulcate (narrow, deep furrows or radial grooves –like spokes on a wheel). The mature colony has a central greyish-turquoise to greyish-orange colour with a white periphery (outer edge). Exudates (extrolites) are frequently produced which appear as drops of liquid upon the surface of the colony. These may appear clear, to pale yellow, to a reddish-brown in colour. Some strains may also produce a soluble pigment which can diffuse into the surrounding medium. The reverse is a pale yellow to a light yellow-brown. Colours and growth characteristics are, of course, media and strain dependent. Penicillium citrinum on Saboraud Dextrose Agar (SAB) after ~7 days incubation at 30ᵒC (Nikon)
Penicillium citrinum-SAB, 14 days incubation at 30ᵒC (Nikon)
Note the drops of exudate (extrolites) which have formed on the surface.
Colour variation due to maturing of colony but also a difference in my lighting for photography.
Exudates (or Extrolites): Some fungi can produce exudates as a by-product of their growth, many of which can be collected for commercial use. Mycotoxins are by-products (secondary metabolites) which are potent poisons. Penicillium citrinum produces Citrinin, a nephrotoxic mycotoxin which derives its name from the fungus. It may also produce other extrolites such as tanzowaic acid A, quinolactacins, quinocitrinines, asteric acid and compactin.
Microscopic Morphology: Penicillium citrinumproduces septate, hyaline (clear, not pigmented) hyphae. Smooth-walled conidiophores stipes are rather long (100 – 300 µm) and is biverticillate (see diagram at end of post). Metulae are 12 – 15 µm in length which are found in whorls of 3 – 5 divergent structures. Phialides are ampuliform (flask-shaped) and about 7 – 12 µm in length. Conidia (2.2 – 3.0 µm dia.) are globose to sub-globose (round to off-round) and are smooth or have a finely roughened surface. Conidia resist disruption and form rather long chains. These characteristics: the metulae longer than the phialides and the conidia being both spherical and produced in well-defined chains, are distinguishing features of Penicilliumcitrinum.
Penicillium citrinum- distinguishing features of Penicillium'species' can already be made out at low magnification. (250X, LPCB, DMD-108)
Penicillium citrinum- distinguishing features of Penicillium'species' much more evident at 400X.
Typical "fingers" made up of the metulae and phialide structures from which chains of conidia extend. (400X, LPCB, DMD-108)
Penicillium citrinum- a mass of overlapping fruiting structures with copious amounts of conidia.
(1000X, LPCB, DMD-108)
Penicillium citrinum- a little less congested in this photo. Conidiophores (stipes) seen from which extend the metulae and conidia producing phialides. Conidia are globose (round) to sub-globose (somewhat off-round) in shape, (1000X, LPCB, DMD-108)
Penicillium citrinum- long metulae and the somewhat shorter phialides are clearly distinguishable in this photograph. The conidia are generally smooth or can have a finely roughened surface.
(1000+10X, LPCB, DMD-108)
Penicillium citrinum- another view.
(1000+10X, LPCB, DMD-108)
Penicillium citrinum- exhibits biverticillate branching meaning that the conidiophore can branch and the metulae & phialides extend from these branches. Triverticillate would have the conidia branching and then the branches also branching to finally produce the metulae & phialide fruiting structures.
(1000X, LPCB, DMD-108)
Penicillium citrinum- Phialides are ampuliform (flask-shaped) and about 7 – 12 µm in length. Again, conidia (2.2 – 3.0 µm dia.) are globose to sub-globose (round to off-round) and are smooth or have a finely roughened surface. (1000+10X, LPCB, DMD-108)
Penicillium citrinum- Here we see the proportions of the metulae (M) and the 'flask-shaped' phialides (P) with the metulae being substantially longer than the phialides, The biverticillate structure is evident in this photo. (ie. each branch extending from the conidiophore (stipe), branches only once and then bears a fruiting structure consisting of the metulae and phialides.
(1000+10X, LPCB, DMD-108)
Penicillium citrinum- another example.
(1000+10X, LPCB, DMD-108)
Penicillium citrinum- a few more photos to finish up.
(1000+10X, LPCB, DMD-108)
Penicillium citrinum- suitable for framing!
(1000X, LPCB, DMD-108)
Penicillium citrinum
(400+10X, LPCB, DMD-108)
Penicillium citrinum
(400X, LPCB, DMD-108)
Penicillium citrinum- another colony showing the exudate (extrolites) which accumulate on the colony surface after extended incubation. These metabolites may be potent poisonous mycotoxins or might have beneficial uses in industrial or pharmaceutical applications. (Nikon)

Physiology: The spores of Penicillium citrinum fail to germinate at 5ᵒC and may show restricted growth at 37ᵒC.
* * *